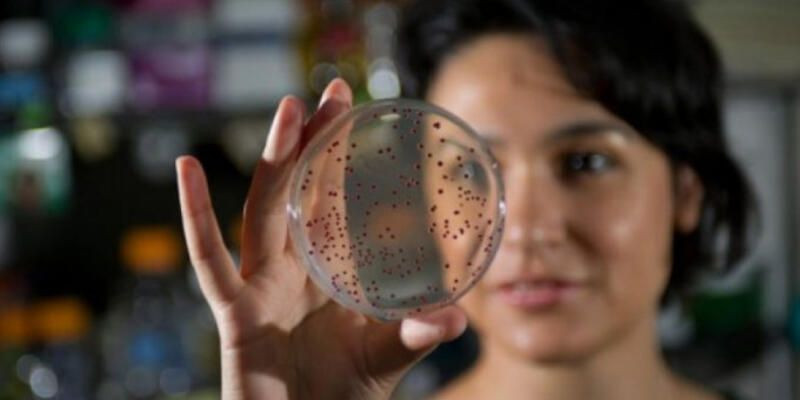
NASA’nın yıldızı oldu! Betül Kaçar 4 milyar yaşındaki bakteriyi canlandırdı Prof. Dr. Betül Kaçar kimdir? - Resim: 1

NASA’nın yıldızı oldu! Betül Kaçar 4 milyar yaşındaki bakteriyi canlandırdı Prof. Dr. Betül Kaçar kimdir?

Prof. Dr. Betül Kaçar... NASA'da görevli bir astrobiyolog... Öyle bir işe imza attı ki hem Türkiye'nin gururu oldu hem de dünya tarihini değiştirebilir. Prof. Dr. Kaçar, 4 milyar yıl öncesine ait bir bakteriyi antik DNA ile klonlayarak tekrar canlandırdı...
Geçen yıl NASA'nın evrende yaşam izleri arayan ekibine dahil olan astrobiyolog Prof. Dr. Betül Kaçar, büyük başarıya imza attı. Prof. Dr. Kaçar, 4 milyar yıl öncesine ait bir bakteriyi antik DNA ile klonlayarak tekrar canlandırdı. Kaçar, fosiller yerine moleküllere odaklanarak geçmiş yaşamın anlaşılmasını sağlayacak yeni bir alan geliştirme çalışmasına başladıklarını Twitter'dan duyurdu.

Evrende yaşamın izini sürüyor
Bilimsel çalışmasıyla büyük bir başarının altına imzasını atan Türk bilim insanı Astrobiyolog Prof. Dr. Betül Kaçar, laboratuvar ortamında canlandırdığı geçmişe dair biyolojik yaşamı, güneş sistemi ve dışındaki gezegenlerden elde edilen verilerle karşılaştırarak evrendeki yaşamın izlerini arıyor.

Kaçar, 2020'de NASA'nın evrende dünya dışında yaşam arama çalışmalarına yön verecek 12 araştırma grubundan oluşan bir ekibin lideri oldu. Bu göreve getirilen ilk Türk olan Kaçar, böylece adını da tarihe altın harflerle yazdırdı.

Prof. Dr. Kaçar, 19 yaşında Marmara Üniversitesi'nde öğrenciyken başvurduğu proje ile Amerikan Howard Hughes Tıp Enstitüsü (HHMI) tarafından ödüllendirilmesinden sonra ABD çalışmalarına başladı.